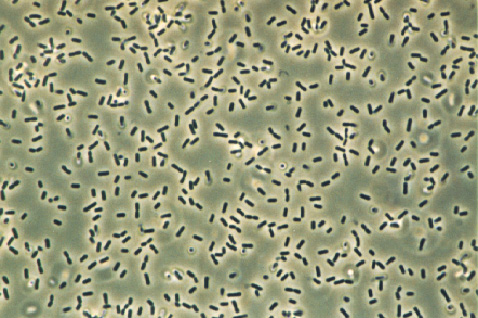
bacillus subtilis

The discovery of the mycorrhizae and their beneficial effects on plant dates back to 1800. These organisms have always been hidden due to the wide use and preference towards chemical origin fertilizers. However, the evolution which today the world is subjected is moving towards a low envionmental impact agriculture and therefore towards an increased respect of the ecosystem. For this reason this kind of solution is an interesting topic in order to achieve a vegetal nutrition that can be attentive to the challenges of the modern agriculture. Mycorrhizae (from Greek: mikes = fungus; rhiza = root) are the symbiotic mutualisticic associations between a plant and a fungus. There are two kind of mycorrizhae: Ectomycorrhizae, colonizers of few plant species, and Endomycorrhizae. Known Endomycorrhizae are about 150 and are able to colonize about the 95% of the vegetal species. They can be found in almost all kinds of environments. They are also called Arbuscular mychorrhizae because they make specialized structures called arbuscules inside the root cells that carry out an important role in the exchange between the fungus and the vegetal host cell. The main characteristic of arbuscular mycorrhizae is the development of the fungus both inside the host plant's roots (intraradical hyphae) and in the soil (extraradical hyphae). Thanks to this hyphae reticulum the mychorrizae produce intra and extrradical spores useful for the propagation of the species and for the overcoming of hostile periods.


In the mycorrhizal symbiosis the plant gives sugars to the fungus while the fungus absorbs and gives nutritional elements to the plant in big quantity. In this way the plant has many benefits, for example:

enormous multiplication of the surface and the root volume (up to 700% more in comparison with a non mychorrized root system).

increase of the absorption capacity of water, macro (especially P) and microelements (thanks to this, it has been proven that mychorrized plants photosynthsize the 25% more than non mychrozzied plants.

higher tolerance to abiotic stresses

action as root biofilter

stimulation of the bacterial activity of the soil, guaranteeing a better fertility property

polluted soil recovery effect
Associated to the mycorrhizae are many useful micro- organisms: the nitrogen-fixators (rhizobium, azotobacter, Bacillus Polymyxa), the PGPR (Plant Growth Promoting Rhizobacteria: Pseudomonas, Streptomyces), nematodes antagonists (Arthtobotrys) and the pathogenic fungus antagonists (Trichoderma).
Bacilli and fungi are absolutely necessary to mychorrhizae, depending on the compatibility, because they promote spores germination, root colonization, mycelium growth, they increase mycorrhizae efficiency in nutrients absorption, they produce phytostimulant action compounds, they carry out an antagonistic action towards many pathogens.

they promote roots colonization
they promote the growth of mycelium
they increase the mycorrhizal efficiency in nutrients absorption
they produce phytostimulant effect compounds
Specific action fertilizers able to naturally develop a big quantity of micro-organisms useful to the development of the plant.
The distinction between Fungi (Actinobacteria) and Bacilli is fundamental to get used to consider and use the two categories in a different way between them.
Acronym of Colony Forming Unity per gram.
For the micro-organisms it has to be determinated the number of cells or vital spores expressed as CFU per gram.
This is a really important coefficient in order to evaluate the intrinsic value of the product. Between a 106 and a 109 there is an enormous difference, 1000 times:
106 = 1.000.000
107 = 10.000.000
108 = 100.000.000
109 = 1.000.000.000
The more the CFU coefficient is high the more efficient and better is the persistence. Of course, there is a gap also between 1x106 and 5x106. So, it is necessary to pay attention to the declarations on the label.
109 = 1.000.000.000
The more the CFU coefficient is high the more efficient and better is the persistence. Of course, there is a gap also between 1x106 and 5x106. So, it is necessary to pay attention to the declarations on the label.

The material used for the conservation of bacteria and fungi is selected in order to reach 2 years of vitality.
To reach this parameter it is clear that the product must be preserved in warehouses protected from extreme temperatures or from unexpected jump in temperatures : from 5° to 25° C max.

Grabi R&D guarantees a continuous evolution of bioactives strains.
All micro-organisms both bacteria and fungi have their own vitality and a conditioning in time.
Therefore, they also evolve in time and for this reason each half year, with our strategy 6 months evolution, we investigate on the dynamism of the strain and on how it can be improved both as focus and specific mission.
For this reason, to leave these strains static it means entering in little governed problems at the mercy of inactivity determined by abiotic or biotic factors.
Products which are dated 1-2 years are no more adequate to the evolution.
These are the 50 strains that Grabi Chemical has in catalogue and in continuous study so that every strain can be always evoluted.



The bioreactor is a controlled environment in which a biochemical reaction occurs and its task is to optimize the organism growth and/or the formation of a product made by the organism. In the bioreactor we can control pH, temperature, oxygenation during the entire process. This kind of bioreactor allows us to have a remarkable homogeneity of the culture broth, high capability of O2 transfer and great flexibility.